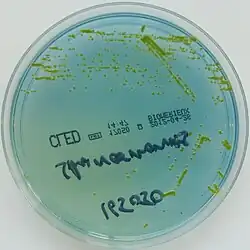

Sphingomonas paucimobilis
| Sphingomonas paucimobilis | |
|---|---|
| Scientific classification | |
| Domain: | Bacteria |
| Kingdom: | Pseudomonadati |
| Phylum: | Pseudomonadota |
| Class: | Alphaproteobacteria |
| Order: | Sphingomonadales |
| Family: | Sphingomonadaceae |
| Genus: | Sphingomonas |
| Species: | S. paucimobilis
|
| Binomial name | |
| Sphingomonas paucimobilis (Holmes et al. 1977)
Yabuuchi et al. 1990 | |
| Synonyms | |
|
Pseudomonas paucimobilis Holmes et al. 1977 | |
Sphingomonas paucimobilis is a strictly aerobic Gram-negative bacterium that has a single polar flagellum with slow motility.[1][2] The cell size is around 0.7 x 1.4 μm.[3] It is usually found in soil. As with the other members of the genus, its biochemistry is remarkable in possession of ubiquinone 10 as its major respiratory quinone, and of glycosphingolipids instead of lipopolysaccharides in its cell envelope.[4] It has been implicated in various types of clinical infections.[2][5][6]
S. paucimobilis is able to degrade lignin-related biphenyl chemical compounds.[7]
References
- ^ Yabuuchi, Eiko; Yano, Ikuya; Oyaizu, Hiroshi; Hashimoto, Yasuhiro; Ezaki, Takayuki; Yamamoto, Hiroyuki (February 1990). "Proposals of Sphingomonas paucimobilis gen. nov. and comb. nov., Sphingomonas parapaucimobilis sp. nov., Sphingomonas yanoikuyae sp. nov., Sphingomonas adhaesiva sp. nov., Sphingomonas capsulata comb. nov., and two genospecies of the genus Sphingomonas". Microbiology and Immunology. 34 (2): 99–119. doi:10.1111/j.1348-0421.1990.tb00996.x. PMID 2111872. S2CID 23019663.
- ^ a b Toh, Han-Siong; Tay, Hung-Tze; Kuar, Wei-Khie; Weng, Tzu-Chieh; Tang, Hung-Jen; Tan, Che-Kim (August 2011). "Risk factors associated with Sphingomonas paucimobilis infection". Journal of Microbiology, Immunology and Infection. 44 (4): 289–295. doi:10.1016/j.jmii.2010.08.007. PMID 21524965.
- ^ George M. Garrity, ed. (July 26, 2005) [1984(Williams & Wilkins)]. The Proteobacteria. Bergey's Manual of Systematic Bacteriology. Vol. 2C (2nd ed.). New York: Springer. ISBN 978-0-387-24145-6. British Library no. GBA561951.
- ^ Sphingomonas, Microbewiki
- ^ Ryan, MP; Adley, CC (2010). "Sphingomonas paucimobilis: a persistent Gram-negative nosocomial infectious organism". J Hosp Infect. 75 (3): 153–7. doi:10.1016/j.jhin.2010.03.007. PMID 20434794.
- ^ Maragakis, Lisa L.; Chaiwarith, Romanee; Srinivasan, Arjun; Torriani, Francesca J.; Avdic, Edina; Lee, Andrew; Ross, Tracy R.; Carroll, Karen C.; Perl, Trish M. (January 2009). "Sphingomonas paucimobilis Bloodstream Infections Associated with Contaminated Intravenous Fentanyl1". Emerging Infectious Diseases. 15 (1): 12–18. doi:10.3201/eid1501.081054. ISSN 1080-6040. PMC 2660711. PMID 19116043.
- ^ Peng, X.; Egashira, T.; Hanashiro, K.; Masai, E.; Nishikawa, S.; Katayama, Y.; Kimbara, K.; Fukuda, M. (July 1998). "Cloning of a Sphingomonas paucimobilis SYK-6 gene encoding a novel oxygenase that cleaves lignin-related biphenyl and characterization of the enzyme". Applied and Environmental Microbiology. 64 (7): 2520–2527. Bibcode:1998ApEnM..64.2520P. doi:10.1128/AEM.64.7.2520-2527.1998. ISSN 0099-2240. PMC 106420. PMID 9647824.
External links